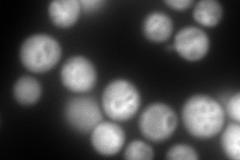

View description
Subunit E of the eight-subunit V1 peripheral membrane domain of the vacuolar H+-ATPase (V-ATPase), an electrogenic proton pump found throughout the endomembrane system; required for the V1 domain to assemble onto the vacuolar membrane
Localization:
Intensity:
Fold change:
Significance:
-
C’ GFP library in SD

vacuole membrane262.23 -
N' NOP1pr-GFP in SD

vacuole membrane416.815 -
N' TEF2pr-mCherry in SD
vacuole membrane515.708 -
N' NATIVEpr-GFP in SD

missing0 -
N' TEF2pr-VC and Cyto-VN in SD

vacuole membrane79.1323 -
C’ GFP library in SD+DTT

vacuole membrane347.931.32No -
C’ GFP library in SD+H2O2

vacuole membrane233.30.88No -
C’ GFP library in Starvation Media

vacuole membrane544.872.07Yes -
C’ GFP library on the background of Pup2-DaMP

vacuole membrane -
C’ GFP library on the background of CCT mutant

vacuole membrane233.3030.889661No
